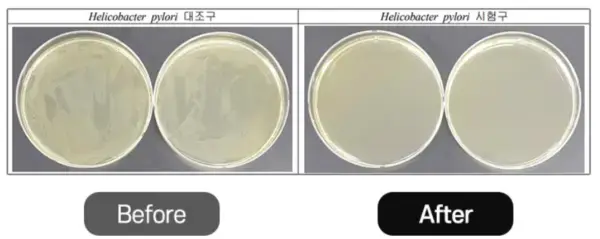

생활하는데 입냄새는 정말 신경쓰이는데요. 다른 사람들에게 안좋은 이미지를 줌은 물론, 중요한 자리에서 첫인상을 싹 구기기 쉽고요. 특히 여자친구 사귀는 장애 요인이 될수도 있습니다.
입냄새 원인은 다양해서 쉽게 안 잡히는 걸로 알고 있는데, 요즘 뜨고 있는 가글이 편도결석을 잡아줘 입냄새제거를 해주는 거 같더라고요.
바로, 디엔테 가글인데요. 그것이 정말인지 여기서 효과와 후기에 대해 알아볼게요.
디엔테 가글, 뭐야?

디엔테 가글은 디엔테 브랜드가 입냄새 제거를 위해 만든 무알콜 약산성 가글로, 플루오르화나트륨과 염화세틸피리디늄을 주성분으로 만든 제품인데요.
플루오르화 나트륨은 식약처로부터 기능성이 인정된 성분이며, 이 제품은 입냄새의 주범인 헬리코박터균을 효과적으로 제거해 입냄새를 없애주는 제품으로, 공식 명칭은 디엔테 데일리 가글입니다.
판매사는 오로지 입냄새를 잡기 위해 노력해오고 있으며, 이 제품을 한달간 써보고도 조금의 효과도 느끼지 못한다면 100%환불 보장을 해줄만큼 품질에 자신감을 보이고 있습니다.
이 제품은 500ml 가글 용액이 흰색바탕에 빨강색 디엔테 로고가 박힌 원통형 병에 담겨져 있습니다.
디엔테 가글, 개발 스토리
우리가 양치질을 아무리 잘해도 25%밖에 안 닦인다고 하는데요.
그래서, 그 부족한 75%를 채우기 위해 개발한 것이 바로 이 가글이랍니다.
이 회사는 아내를 위해 만든 디엔테 잇몸 치약이 런칭후 5만개 완판을 이루었는데, 치약과 함께 쓰면 좋을 구강용품을 고민하던 끝에 이 가글을 개발했다고 해요.
날마다 악취덩어리로 고민하는 고민이신 자극없는 가글을 쓰고 싶어하는 분들을 위해 무알콜 약산성 가글을 만들었다고 합니다.
이 제품은 500ml 가글 용액이 흰색바탕에 빨강색 디엔테 로고가 박힌 원통형 병에 담겨져 있고요.
효과
디엔테 가글의 효과는 기능성 성분인 플루오르화 나트륨과 부가원료에 대한 과학적인 실험 결과로 나타났는데요.
입냄새의 주범으로 알려진 헬리코 박터균을 99.9% 제거해주는 것으로 확인되었습니다.
실험은 입냄새를 유발하는 균을 기능성 성분과 배합후 1분경과후에 균의 농도를 측정해 봤는데요. 사진으로 보면 아래와 같아요
위 사진에서도 알수 있듯이 이 제품으 기능성원료를 사용전에 비해 사용후 1분만에 균이 거의 소멸된 모습으로 볼수 있는데요.
비율로 따지면 입냄새를 유발하는 균인 헬리코박터균이 99.9%가 제거된 것을 알수 있습니다.
이 실험 결과는 결국 디엔테 가글이 입냄새 원인균인 헬리코박터균 제거에 효과가 있음을 증명해낸 것입니다.
성분 효능
디엔테 가글은 플루오르화 나트륨과 염화세틸 피리디늄을 주원료로 만들었는데요.
플루오르화 나트륨은 식약처가 공식 인정한 기능성 성분으로, 치아틈새에 끼어 있는 찌꺼기를 빠르게 배출하여 충치예방과 악취제거에 효과가 있는 성분입니다.
역시 식약처 인정 기능성 성분인 염화세틸 피리디늄은 항염, 항균 작용을 하며 치아의 치태 제거와 치은염을 효과적으로 예방해 줍니다.
부가성분으로 구강건조를 개선해줄수 있는 병풀추출물과 입냄새 제거에 좋은 녹차추출물과 거의 완벽에 가까운 입냄새제거 효과가 있다는 프로폴리스, L-멘톨, 페퍼밑트 오일 등이 들어 있어 구취제거에 도움을 줄것으로 보입니다.
결론적으로, 이 가글 제품으로 얻을수 있는 전체 효과는 충치예방, 구취제거, 구강정화, 치태(프라그)제거, 치은몀 예방 입니다.
이외, 편도결석도 입냄새의 원인이 되는데요. 편도결석개선은 꾸준한 관리가 필수라고 합니다. 후기 효과를 살펴 보니 편도선 결석에도 효과가 있다고 하니, 아래에서 후기도 꼼꼼히 살펴 보세요.
안전성
성분은 다 좋은데, 제대로 만들었는지 걱정되실수 있는데요.
이 제품은 식약처로부터 제조과정까지 인정 받았으므로, 안심하고 사용하셔도 된다고 합니다.
또 유해한 17가지 성분을 모두 첨가하지 않아, 더 안심하고 사용하실수 있다고 합니다.
무첨가한 17가지에는 설페이트 계면활성제 4종, 파라벤 6종, 타르색소 7종이라고 하네요.
후기 엿보기
- 다른 가글에 비해 자극이 없고 가글 직후 정말 개운함.
- 가글 덕인지 모르겠지만, 목이 훨씬 깨끗해졌음.
- 감기걸리고 불쾌해서 해 봤더니, 편도결석이 엄청 나온후로 불쾌한 냄새 안 느껴짐.
- 가글할때마다 입안에서 계속 거품이 나와서 계속은 못했는데, 결석 있을때 가글을 하면 2~3일만에 결석이 나옴.
- 편도결석 때문에 목이 주기적으로 붓고 아팠는데, 디엔테 가글 3일 사용후 편도결석 나왔고 4일째에도 결석이 또 나왔음. 또 상쾌하고 맵거나 화하지 않아서 좋음
- 사용한지 2주 됐는데, 결석이 눈에 띠게 줄었고, 결석으로 인해 나던 특유의 냄새도 줄었음.
- 치석까지 제거되는지는 아직 잘 모르겠고, 입냄새 제거에는 일단 효과 있는거 같음.
후기를 더 보고 싶으시다면, 아래 링크를 클릭하시면 솔직후기를 몰아 보실수 있으니, 참고해 보세요.
정리
지금까지 디엔테 가글에 대해서 알아봤는데요.
입냄세의 원인균인 헬리코박터균을 99.9% 제거해 준다니 헬리코박터균 때문에 입냄새가 나시는 분들은 바로 입냄새 제거 효과를 보실거 같아요.
입냄새의 원인이 편도결석이 원인이 되기도 한다는데, 이 경우에도 후기를 보면 결석이 있었던 분들은 대부분 결석이 빠진다고 하니, 이 경우 역시 입냄새 제거에 도움이 되실수 있겠네요.
기타, 이 제품의 효과는 성분 효능편에 있는 것처럼, 플라그제거, 치은염 예방, 충치예방, 구강정화 등의 효과가 있다고 하는데요.
후기를 꼼꼼히 살펴 보시고 필요한 고민부분 해결이 확신이 서실때 구매하시기 바랍니다.
'건강' 카테고리의 다른 글
| 비브셀 라하필 LHA 효과 성분 사용법 궁금증까지 정리 (0) | 2024.04.11 |
|---|---|
| 귀리 이렇게 좋았어? 효능 먹는법 주의 사항 후기 (0) | 2024.04.08 |
| BK 심부 발열기 뭐지? 사용법 효과 주의사항 (0) | 2024.04.04 |
| 슬룸 목편한케어 자면서도 돼? 효과 사용법 후기 (0) | 2024.04.03 |
| 풀리오 목 어깨 마사지기 내돈내산 뭉친피로, 어깨라인 고민된다면? (0) | 2024.04.02 |